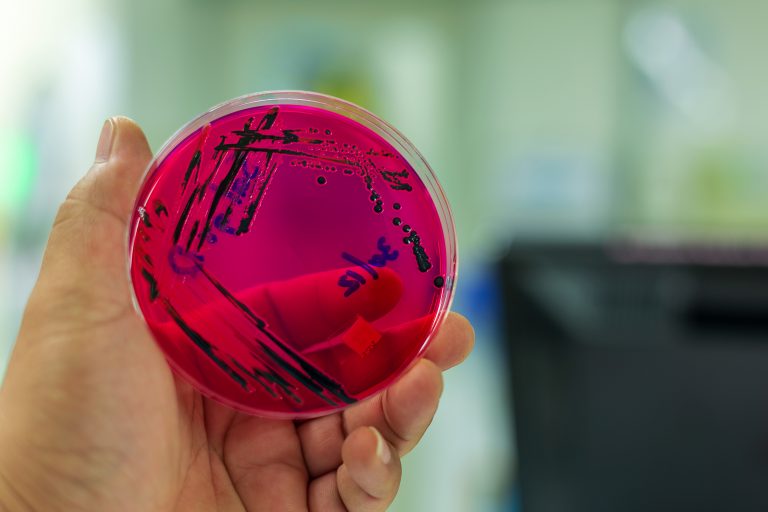
Sepsis: essential information on the UK’s hidden killer

Sepsis: essential information on the UK’s hidden killer
This article was taken from:https://www.theguardian.com/modern-healthcare-challenges/2019/oct/07/sepsis-essential-information-on-the-uks-hidden-killer By Sue George, Guardian News It is estimated to kill more people a year in the UK than breast, bowel and prostate cancer combined, but awareness of sepsis and its effects remains disproportionately low. So why are so many people dying from the condition, and what is being done to…